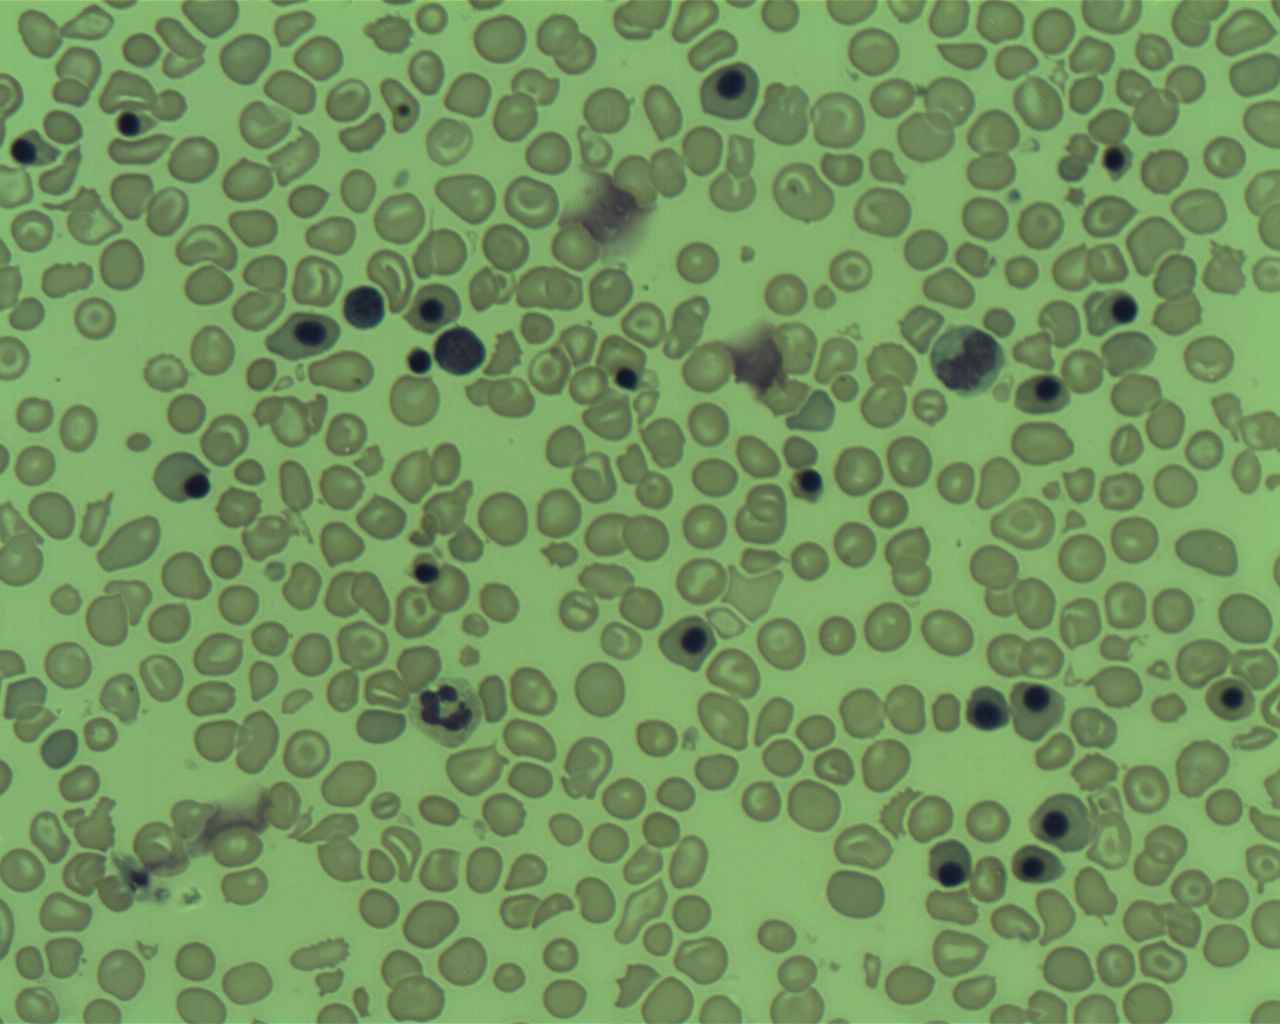

Innovative Medicines Initiative approves €40 million HARMONY project for better care of patients with hematologic malignancies
The Innovative Medicines Initiative (IMI) has approved HARMONY, a project that aims to foster better access and care for patients with various hematologic malignancies (HM) with the use of big data. The project is made up of 51 partners from 11 European countries, including 7 pharmaceutical companies.
HARMONY will capture, integrate, analyze and harmonize anonymous patient data from high-quality multidisciplinary sources to unlock valuable knowledge on multiple myeloma (MM), acute myeloid leukemia (AML), acute lymphoblastic leukemia (ALL), chronic lymphocytic leukemia (CLL), non-Hodgkins lymphoma (NHL), myelodysplastic syndromes (MDS) and pediatric HMs.
Building on pre-existing, long-lasting collaborations between Academic institutes and the pharmaceutical industry, the HARMONY project shall further advance HM management through a more efficient process of treatment development and rapid decision-making. The expected outcome will be better prognosis and quicker life-saving decisions, important for patients suffering from these hematological diseases.
The project brings together key stakeholders in the clinical, academic, patient, HTA (health technology assessment), regulatory, economical, ethical and pharmaceutical fields to:
- Developing a data sharing platform that empowers clinicians and policy stakeholders to improve decision-making
- Establishing a network reflecting the European HMs landscape
- Defining clinical endpoints and standard outcomes in ALL (paediatric & adult), NHL, MM, AML, CLL, MDS
- Alignment of key stakeholders on relevance of these outcomes (policy makers, payers, patients)
- Providing means for analysing complex data sets comprising different layers of information
- Identifying specific markers for early registration of innovative and effective therapies for HMs
The HARMONY project’s final deliverable is a big data platform which integrates outcome measures and endpoint definitions for HMs. HARMONY will achieve this from a pan-European perspective by uniting and aligning European stakeholders and key opinion leaders in the field. The 5-year project will start in January 2017 and is funded through the Innovative Medicines Initiative (IMI); Europe’s largest public-private initiative aiming to speed up the development of better and safer medicines for patients. Harmony is coordinated by two public leads: Prof. Dr. Jesús Marïa Hernández from Instituto de Investigación Biomédica de Salamanca, Spain, and Dr. Guillermo Sanz from Instituto de Investigación Sanitaria del Hospital La Fe de Valencia, Spain, and by two EFPIA leads, Tayyab Salimullah from Novartis Oncology and Pam Bacon from Celgene International.
Contact information: [email protected]
THE INNOVATIVE MEDICINES INITIATIVE The Innovative Medicines Initiative (IMI) is Europe’s largest public-private initiative aiming to speed up the development of better and safer medicines for patients. IMI supports collaborative research projects and builds networks of industrial and academic experts in order to boost pharmaceutical innovation in Europe. IMI is a joint undertaking between the European Union and the pharmaceutical industry association EFPIA.
Partners in HARMONY
Project management
Instituto de Investigación Biomédica de Salamanca (IBSAL), Spain
Instituto de Investigación Sanitaria del Hospital La Fe de Valencia (HULAFE), Spain
Celgene International II SARL, Switzerland
Novartis, Switzerland
Synapse Research Management Partners, S.L. (SYNAPSE), Spain
Partners
Universitaet Ulm (UULM), Germany*
Alma Mater Studiorum – Università di Bologna (UNIBO), Italy*
European Hematology Association (EHA), The Netherlands*
ELN Foundation (ELN), Germany*
GMV Soluciones Globales Internet S.A.U. (GMV), Spain*
European Alliance for Personalised Medicine (EAPM), Belgium
Medizinische Universitaet – Wien (MUW), Austria*
Erasmus Universiteit Medisch Centrum Rotterdam (EMC), The Netherlands
University of Navarra (UNAV), Spain
Università degli Studi di Torino (UNITO), Italy
Stichting VUmc, The Netherlands
The Chancellor, Masters and Scholars of the University of Cambridge (UCAM), United Kingdom
University of Rome ‘Tor Vergata’ (URTV), Italy
Goethe University Frankfurt (GUF), Germany
Group for Research on Adult Acute Lymphoblastic Leukemia (GRAALL), France
Jose Carreras Leukaemia Research Institute (IJC), Spain
European Research Initiative on CLL e.v. (ERIC), Germany
Masaryk University (MU), Czech Republic
Fundacio privada Institut D’investigacio Oncologica de Vall-Hebron (VHIO), Spain
The Lymphoma Scientific Association (LYSA), France
Ludwig-Maximilians-Universitaet – Muenchen (LMU-Muenchen), Germany
Barts Health NHS Trust (BHT), United Kingdom
Groupe Francophone des Myélodysplasies (GFM), France
Heinrich-Heine-Universitaet – Duesseldorf (UDUS), Germany
Fondazione Italiana per lo studio delle sindromi mielodisplastiche onlus (FISMonlus), Italy
University of Newcastle upon Tyne (UNEW), United Kingdom
German Society of Pediatric Oncology-Hematology GmbH gemeinnützig (GPOH), Germany
Ospedale Pediatrico Bambino Gesù (OPBG), Italy
University of York (UoY), United Kingdom
European Organisation for Research and Treatment of Cancer (EORTC), Belgium
European Society for Blood and Marrow Transplantation (EBMT), The Netherlands
Flanders Institute of Biotechnology (VIB), Belgium
University of Helsinki (UH), Finland
Assistance Publique – Hôpitaux de Paris (AP-HP), France
Genome Research Limited (GRL-SANGER), United Kingdom
MediSapiens Ltd (MS), Finland
MLL Munich Leukemia Laboratory GmbH (MLL), Germany
LeukaNET (LeNET), Germany*
National Institute for Health and Care Excellence (NICE), United Kingdom
Agencia Española de Medicamentos y Productos Sanitarios (AEMPS), Spain
Bundesinstitut für Arzneimittel und Medizinprodukte (BfArM), Germany
Amgen, United Kingdom*
Janssen Pharmaceutica NV, Belgium*
Bayer Aktiengesellschaft, Germany*
Menarini Ricerche S.p.A., Italy*
Takeda, United Kingdom*
*Work package leaders and co-leaders
Source: www.ehaweb.org